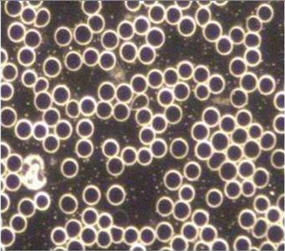

top of page

Services
1 hr 30 min
45 min
Incl. in Testing app1 hr
From 199 Australian dollars45 min
$318-35545 min
22 Australian dollars45 min
299 Australian dollars- Read More
The most comprehensive gut DNA test available for peak digestive and immune health.
45 min
485 Australian dollars
bottom of page